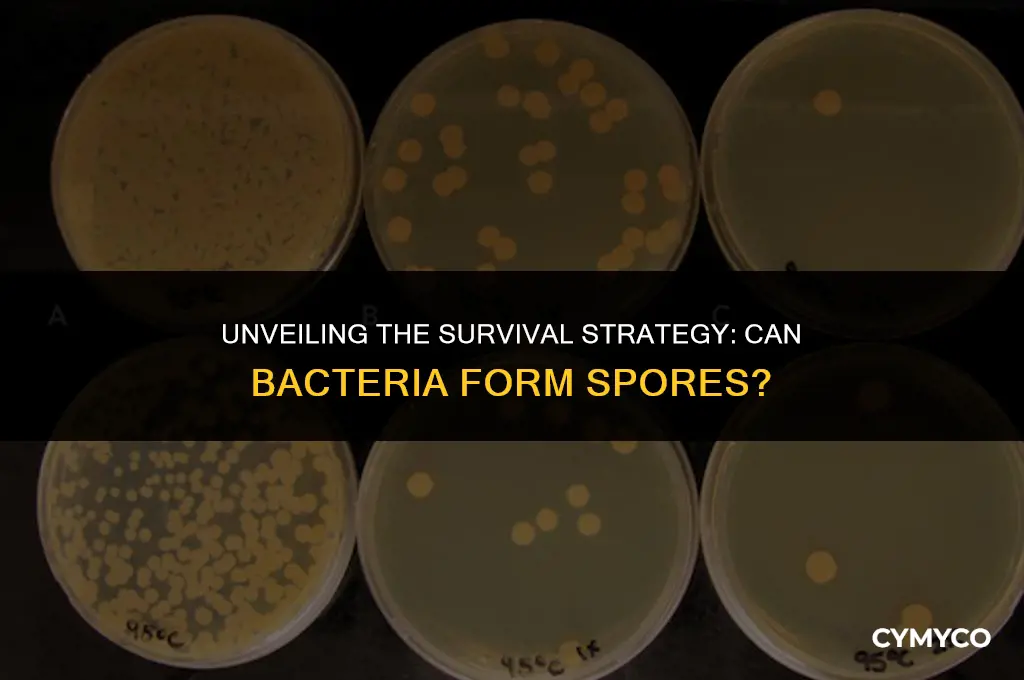
can bacteria form spores

Bacteria, as single-celled microorganisms, have evolved various strategies to survive and reproduce in diverse environments. One such strategy is the formation of spores, which are highly resistant, dormant structures that can withstand extreme conditions such as high temperatures, radiation, and desiccation. Spores allow bacteria to remain viable for extended periods, enabling them to disperse and colonize new habitats. This remarkable adaptation is observed in several bacterial genera, including Bacillus and Clostridium, which are known for their ability to produce endospores. The process of spore formation involves a complex series of morphological and biochemical changes, resulting in the creation of a protective outer layer that encases the bacterial cell. Upon encountering favorable conditions, spores can germinate, reverting back to their vegetative state and resuming growth and reproduction. The ability of bacteria to form spores has significant implications for various fields, including microbiology, biotechnology, and medicine, as it contributes to our understanding of bacterial survival, pathogenicity, and the development of effective sterilization and preservation methods.
Explore related products
$489.46 $589.95
What You'll Learn
- Definition of Spores: Understand what bacterial spores are and their significance in bacterial life cycles
- Conditions for Spore Formation: Explore the environmental triggers that lead bacteria to form spores, such as nutrient depletion
- Types of Bacterial Spores: Discover different kinds of spores formed by various bacteria, including endospores and exospores
- Spore Structure and Composition: Delve into the physical and chemical makeup of bacterial spores, including their protective layers
- Germination Process: Learn how bacterial spores can return to their vegetative state under suitable conditions, such as the presence of nutrients

Definition of Spores: Understand what bacterial spores are and their significance in bacterial life cycles
Bacterial spores are a fascinating aspect of bacterial life cycles, representing a highly resistant and dormant stage that allows bacteria to survive extreme conditions. These spores are typically formed in response to environmental stressors, such as nutrient depletion, high temperatures, or the presence of antibiotics. By entering this dormant state, bacteria can remain viable for extended periods, sometimes even for millions of years, until conditions become favorable for germination and growth.
The formation of spores is a complex process that involves the condensation of the bacterial cell's genetic material into a compact structure, surrounded by multiple layers of protective membranes. These layers provide the spore with its remarkable resistance to physical, chemical, and biological insults. For example, bacterial spores can withstand temperatures exceeding 100°C, exposure to UV radiation, and the presence of harsh chemicals that would be lethal to vegetative bacterial cells.
One of the most well-known spore-forming bacteria is Clostridium difficile, a pathogen that causes severe gastrointestinal infections in humans. The spores of C. difficile are particularly problematic in healthcare settings, as they can survive on surfaces for months and are resistant to many disinfectants, making them difficult to eradicate. Understanding the biology of bacterial spores is therefore crucial for developing effective strategies to prevent and treat infections caused by spore-forming pathogens.
In addition to their role in bacterial survival and disease transmission, spores also have important applications in biotechnology and medicine. For instance, spores can be used as vectors for delivering vaccines or therapeutic agents, as they are stable and can be easily produced and stored. Furthermore, some spore-forming bacteria, such as Bacillus subtilis, are used in the production of enzymes and other biotechnological products, taking advantage of their ability to produce large quantities of spores that can be easily purified and processed.
In conclusion, bacterial spores are a remarkable adaptation that allows bacteria to survive and thrive in a wide range of environments. Their unique properties make them both a challenge and an opportunity in various fields, from healthcare to biotechnology. By understanding the biology and significance of bacterial spores, we can develop new strategies to combat infections, improve biotechnological processes, and harness the potential of these fascinating structures for a variety of applications.
Spore Syringe Shelf Life: How Long Does It Last?
You may want to see also
Explore related products

Conditions for Spore Formation: Explore the environmental triggers that lead bacteria to form spores, such as nutrient depletion
Bacteria form spores as a survival strategy in response to various environmental stressors. One of the primary triggers for spore formation is nutrient depletion. When bacteria exhaust their food sources, they enter a state of dormancy to conserve energy and protect their genetic material. This process allows them to withstand harsh conditions until more favorable circumstances arise.
Another significant factor that induces spore formation is the presence of antibiotics. When bacteria detect these antimicrobial agents, they can initiate the sporulation process as a means of resistance. The spores are more resilient to antibiotics than the vegetative cells, enabling them to survive and potentially cause persistent infections.
Temperature also plays a crucial role in spore formation. Many bacteria, such as Clostridium difficile, form spores in response to high temperatures. This heat-induced sporulation is a protective mechanism that allows the bacteria to survive in extreme environments and spread more effectively.
In addition to nutrient depletion, antibiotics, and temperature, other environmental factors like pH levels, oxygen availability, and osmotic pressure can also influence spore formation. For instance, some bacteria may form spores in low-pH environments or when oxygen levels are limited. Understanding these various triggers is essential for developing effective strategies to control bacterial infections and prevent the spread of spore-forming pathogens.
Ozone's Power: Effectively Eliminating Mold Spores in Your Environment
You may want to see also
Explore related products

Types of Bacterial Spores: Discover different kinds of spores formed by various bacteria, including endospores and exospores
Bacteria have evolved various strategies to survive harsh environmental conditions, and one such strategy is the formation of spores. These spores are highly resistant structures that can withstand extreme temperatures, radiation, and chemical insults. There are two main types of bacterial spores: endospores and exospores.
Endospores are formed within the bacterial cell and are surrounded by a protective cortex layer. They are typically smaller than exospores and are released when the bacterial cell lyses. Endospores are highly resistant to environmental stresses and can remain viable for millions of years. Examples of bacteria that form endospores include Bacillus anthracis, which causes anthrax, and Clostridium botulinum, which produces the botulinum toxin.
Exospores, on the other hand, are formed outside the bacterial cell. They are larger than endospores and are often surrounded by a protective sheath. Exospores are also highly resistant to environmental stresses, but they are typically less resistant than endospores. An example of a bacterium that forms exospores is Mycobacterium tuberculosis, which causes tuberculosis.
The formation of spores is a complex process that involves the activation of specific genes and the production of specialized proteins. The process is regulated by various environmental factors, such as temperature, pH, and nutrient availability. Understanding the mechanisms of spore formation is important for the development of new strategies to control bacterial infections and for the preservation of bacterial cultures.
In conclusion, bacterial spores are highly resistant structures that allow bacteria to survive harsh environmental conditions. There are two main types of bacterial spores: endospores and exospores. Endospores are formed within the bacterial cell and are highly resistant to environmental stresses, while exospores are formed outside the bacterial cell and are less resistant. The formation of spores is a complex process that is regulated by various environmental factors.
Can Alcohol Effectively Eliminate Mold Spores? A Comprehensive Guide
You may want to see also
Explore related products

Spore Structure and Composition: Delve into the physical and chemical makeup of bacterial spores, including their protective layers
Bacterial spores are highly specialized structures that enable certain bacteria to survive extreme conditions. These dormant forms are characterized by their remarkable resilience and ability to withstand harsh environmental stresses, such as high temperatures, radiation, and desiccation. The physical and chemical makeup of bacterial spores is crucial to their protective capabilities.
The structure of a bacterial spore typically consists of several distinct layers. The innermost layer is the core, which contains the bacterial chromosome and other essential genetic material. Surrounding the core is the cortex, a thick layer of peptidoglycan that provides structural support and protection. The cortex is followed by the coat, a proteinaceous layer that forms a rigid shell around the spore. This coat is composed of various proteins, including spore-specific proteins and enzymes that contribute to the spore's protective properties.
One of the most critical components of the spore structure is the exosporium, the outermost layer that encases the entire spore. The exosporium is a lipid-rich membrane that acts as a barrier against environmental stressors, such as heat, radiation, and chemicals. This layer is highly impermeable, preventing the entry of harmful substances and the loss of essential cellular components.
The composition of bacterial spores also includes various protective compounds, such as dipicolinic acid (DPA) and pyridine-2,6-dicarboxylic acid (PDC). These molecules are thought to play a role in stabilizing the spore's structure and protecting its genetic material from damage. Additionally, spores may contain small amounts of water, which is essential for maintaining their viability.
In conclusion, the physical and chemical makeup of bacterial spores is a complex and highly specialized system that enables these microorganisms to survive extreme conditions. The protective layers, including the cortex, coat, and exosporium, along with the presence of protective compounds, contribute to the remarkable resilience of bacterial spores. Understanding the structure and composition of spores is essential for developing effective strategies to control and prevent the spread of spore-forming bacteria.
Unveiling the Mysteries of Spores in The Last of Us Saga
You may want to see also
Explore related products

Germination Process: Learn how bacterial spores can return to their vegetative state under suitable conditions, such as the presence of nutrients
Bacterial spores are remarkably resilient structures that allow bacteria to survive in harsh conditions. When the environment becomes favorable, these spores can germinate and return to their vegetative state. This process is crucial for the survival and propagation of many bacterial species.
The germination process begins when the spore encounters suitable conditions, such as the presence of nutrients, water, and a favorable temperature. These conditions trigger the spore to absorb water, causing it to swell and eventually break open. The genetic material inside the spore is then released and begins to function, leading to the formation of a new bacterial cell.
One of the key factors in the germination process is the presence of nutrients. Bacteria require a variety of nutrients to grow and reproduce, including carbon, nitrogen, phosphorus, and various vitamins and minerals. When these nutrients are available, they provide the energy and building blocks necessary for the spore to germinate and the new bacterial cell to grow.
The germination process can vary significantly between different bacterial species. Some species may require specific nutrients or environmental conditions to germinate, while others may be more adaptable. Additionally, the rate of germination can vary widely, with some spores germinating within minutes and others taking days or even weeks.
Understanding the germination process is important for a variety of applications, including food safety, medical treatment, and environmental management. By controlling the conditions that trigger germination, it is possible to prevent the growth of harmful bacteria or to promote the growth of beneficial bacteria.
In conclusion, the germination process is a complex and fascinating aspect of bacterial biology. It allows bacteria to survive in harsh conditions and to rapidly adapt to changing environments. By studying this process, we can gain valuable insights into the behavior of bacteria and develop new strategies for controlling their growth and activity.
How Long Can Mold Spores Survive Without Moisture?
You may want to see also
Frequently asked questions
No, not all bacteria can form spores. Spore formation is a characteristic of certain bacterial species, such as Bacillus and Clostridium.
Bacterial spores are highly resistant, dormant structures produced by certain bacteria. They contain the genetic material and a small amount of cytoplasm, surrounded by a protective spore coat.
Bacteria form spores as a survival mechanism. Spores can withstand extreme environmental conditions, such as high temperatures, radiation, and desiccation, allowing the bacteria to survive in harsh environments.
Bacterial spores germinate when they encounter favorable environmental conditions. The spore absorbs water, swells, and the spore coat ruptures. The genetic material is then released, and the bacterium begins to grow and divide.
Some bacterial spores can be harmful to humans. For example, the spores of Clostridium botulinum can cause botulism, while the spores of Bacillus anthracis can cause anthrax. However, not all bacterial spores are pathogenic.











































